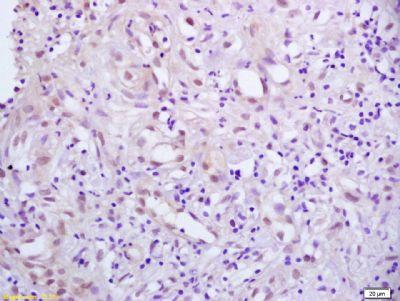
Phospho-PPAR Gamma (Ser273) Antibody in Immunohistochemistry (Paraffin) (IHC (P))

Search
Bioss
Phospho-PPAR Gamma (Ser273) Polyclonal Antibody
{{$productOrderCtrl.translations['antibody.pdp.commerceCard.promotion.promotions']}}
{{$productOrderCtrl.translations['antibody.pdp.commerceCard.promotion.viewpromo']}}
{{$productOrderCtrl.translations['antibody.pdp.commerceCard.promotion.promocode']}}: {{promo.promoCode}} {{promo.promoTitle}} {{promo.promoDescription}}. {{$productOrderCtrl.translations['antibody.pdp.commerceCard.promotion.learnmore']}}
图: 1 / 7
Phospho-PPAR Gamma (Ser273) Antibody (BS-4888R) in IHC (P)







产品信息
BS-4888R
种属反应
宿主/亚型
分类
类型
抗原
偶联物
形式
浓度
规格
纯化类型
保存液
内含物
保存条件
运输条件
靶标信息
This gene encodes a member of the peroxisome proliferator-activated receptor (PPAR) subfamily of nuclear receptors. PPARs form heterodimers with retinoid X receptors (RXRs) and these heterodimers regulate transcription of various genes. Three subtypes of PPARs are known: PPAR-alpha, PPAR-delta, and PPAR-gamma. The protein encoded by this gene is PPAR-gamma and is a regulator of adipocyte differentiation. Additionally, PPAR-gamma has been implicated in the pathology of numerous diseases including obesity, diabetes, atherosclerosis and cancer. Alternatively spliced transcript variants that encode different isoforms have been described.
仅用于科研。不用于诊断过程。未经明确授权不得转售。
篇参考文献 (0)
生物信息学
蛋白别名: HUMPPARG; nuclear receptor; Nuclear receptor subfamily 1 group C member 3; OTTHUMP00000185032; OTTHUMP00000185036; peroxisome proliferator; peroxisome proliferator activated receptor; peroxisome proliferator activated receptor gamma; peroxisome proliferator activated receptor gamma 1 protein; peroxisome proliferator activated receptor gamma 2; peroxisome proliferator activated receptor gamma 4; peroxisome proliferator activator receptor, gamma; Peroxisome proliferator-activated receptor gamma; peroxisome proliferator-activated receptor-gamma 5; peroxisome proliferator-activated receptor-gamma splicing; PPAR gamma; PPAR-gamma; PPARy; unnamed protein product
基因别名: CIMT1; FPLD3; GLM1; NR1C3; PPAR gamma; PPAR-gamma; PPAR-gamma2; PPARG; PPARG1; PPARG2; PPARG5; PPARgamma; PPARgamma2
UniProt ID: (Human) P37231, (Mouse) P37238, (Rat) O88275
Entrez Gene ID: (Sheep) 443513, (Human) 5468, (Guinea pig) 100729138, (Mouse) 19016, (Rat) 25664